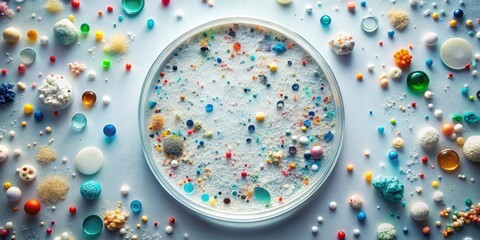
A Microscopic World of Colorful Particles and Aggregates in a Petri Dish

Ningún producto
Estos precios se entienden IVA incluído
Se ha añadido un nuevo artículo a tu cesta.
¡Buen Trabajo!
Se ha añadido un nuevo artículo a tu cesta.
Artículos en su carrito. 1 Artículo en su carrito.
- #221674131

- #602394571

- #614010101

- #1786149996

- #1801717827

- #1830122737

- #1848693462

- #811842375

- #993910786

- #324787465

- #831489013

- #757406091

- #761650730

- #1547026419

- #1794292704

- #1888433318
- #55246872

- #1386008750

- #502590469

- #1870394823

- #494456403

- #1540431938

- #1831293743

- #1558821989

- #526445021

- #20134003

- #1627176745

- #811842289

- #1928652625

- #330132813

- #1907381745

- #684700557

- #1792590950

- #1804564390

- #1386894328

- #1940569147

- #765888963

- #948386708

- #1631623187

- #1002598295

- #494239534

- #677834006

- #651710772

- #817569040

- #614011014

- #717556226

- #130824738

- #1746749809

- #1895123852

- #1834489571

More info
Con las fotos en cartón pluma o FOAM estarás imitando la forma de imprimir fotos en cartón pluma de los fotógrafos profesionales. Y es que la calidad de la impresión es mayor a la impresión directa.
Hay que tener en cuenta que los cuadros de cartón pluma no retienen el enfoque y colores como el papel fotográfico.
Otra de las características de las fotos en cartón pluma es que cuenta con microlaminas imperceptibles a la vista que hace que el producto no se curve.
Cómo personalizar tus cuadros de cartón pluma
Sube tu foto
Para conseguir tu marco de fotos cartón pluma o FOAM, elige una foto de tu ordenador o selecciona alguna de las imágenes de nuestro banco.
Selecciona el tamaño
Escoge el ancho y el alto (en centímetros), de tu cuadro cartón pluma. El mínimo son 50cm y, el máximo, 3000cm.
Las fotos en cartón pluma y precio empezarán desde 13€. En función del tamaño variará.
Características del material
Puedes elegir entre cartón pluma para fotos de 5mm de espesor, o 10mm de espesor.
¿Qué forma te gusta?
Son varias las formas disponibles, además de la normal:
Doble.
Triple.
Cuádruple.
¿Quieres algún efecto?
Por lo que respecta a los efectos, son varias las opciones con las fotos en cartón pluma o FOAM:
Sin efecto.
Blanco y negro.
Sepia.
Frío.
Flip horizontal.
Flip vertical.
Rotar.
Ventajas de las fotos de cartón pluma o FOAM
Ligereza y dureza del material.
Calidad con alta definición.
Diseño a medida.
Versatilidad.
Durabilidad.
¿Cómo colgar los cuadros de cartón pluma?
Colgar los cuadros de cartón pluma te resultará realmente sencillos. Las fotos FOAM cuenta con un colgador que te permitirá colocarlas en cualquier espacio.
¡Consigue tus fotos en cartón pluma online en Rotulatumismo!
Para mas tipos de cuadros Aquí



















